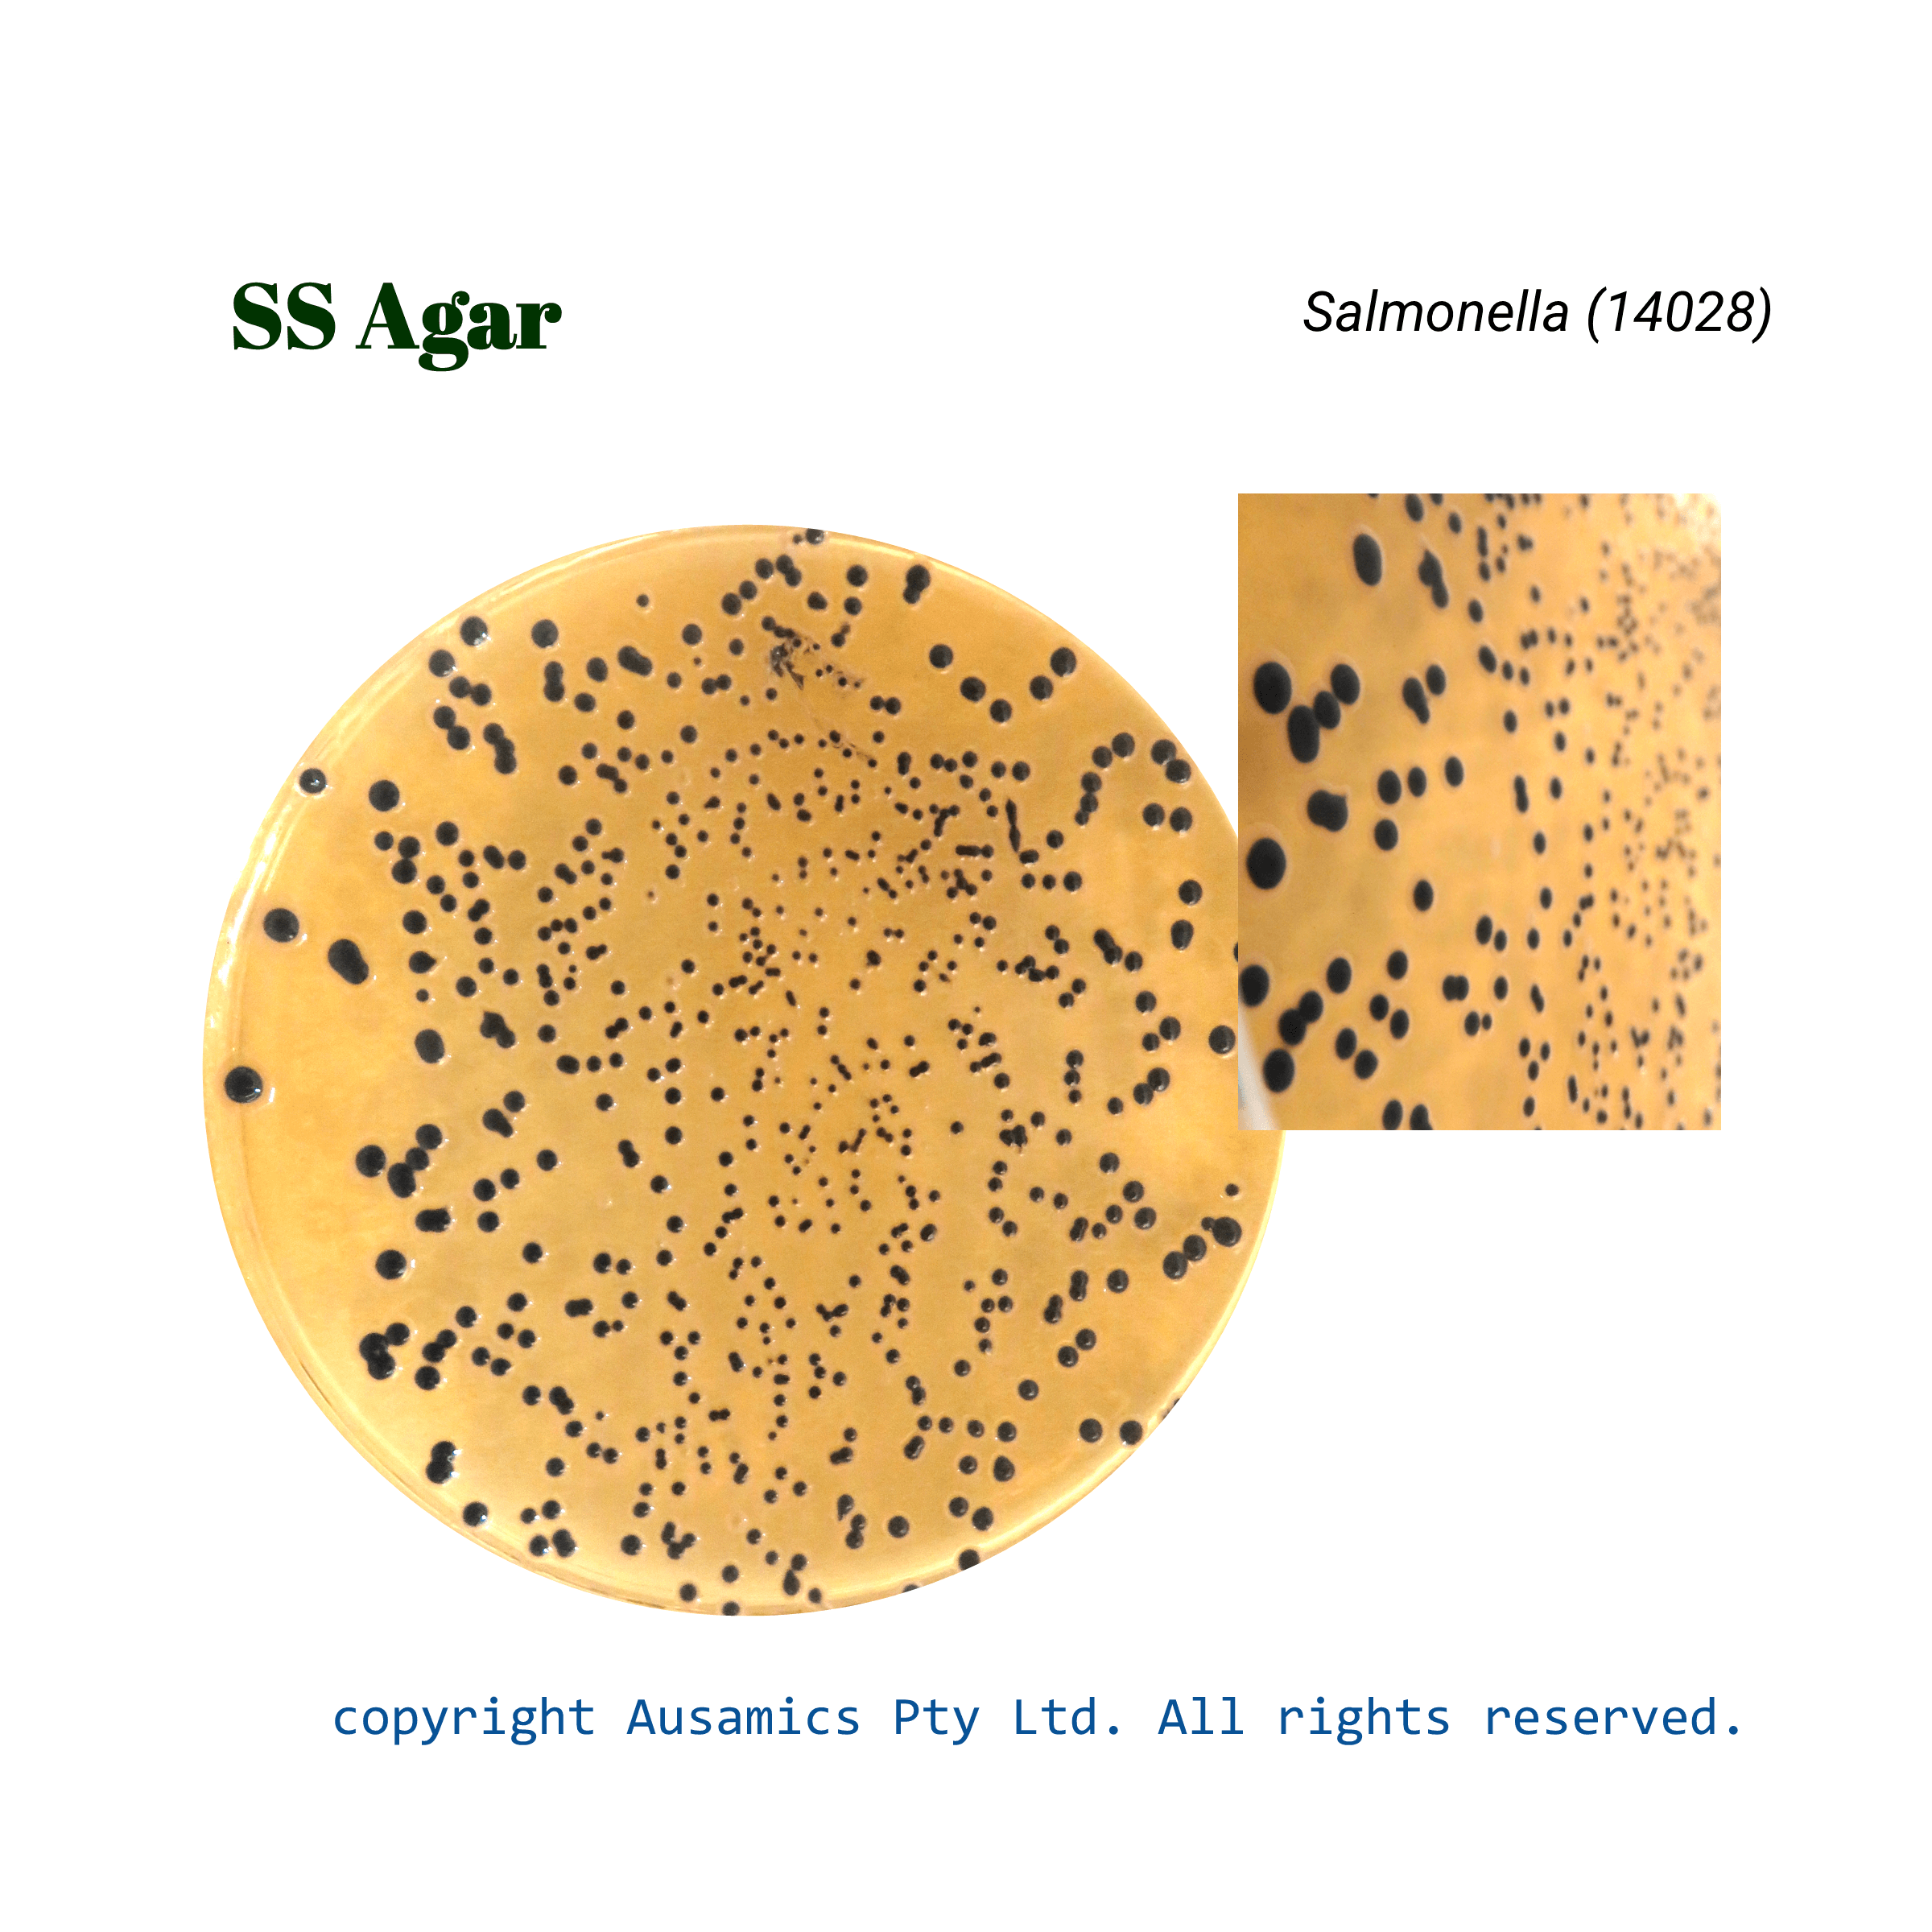
SS_Agar_Salmonella(14028)_Ausamics

Salmonella-Shigella Agar, SS Agar
Salmonella-Shigella Agar, SS Agar, Used for isolating Salmonella and some Shigella.
- Description
- Composition
- Quality Control
- Microbial Test Results
SS Agar is a selective and differential culture medium which is commonly used to isolate Salmonella and Shigella species from food and clinical samples. It is developed to promote the growth of enteric pathogens while preventing the growth of Gram-positive bacteria and most coliforms.
Bile salts, brilliant green, and sodium citrate are used in the medium as selective agents to make the medium inhibitory to undesirable bacteria. Lactose is a carbohydrate that helps distinguish lactose fermenters from non-fermenters, whereas peptones offer a supply of nitrogen. In order to identify hydrogen sulfide generation, which is a trait of some Salmonella serotypes, sodium thiosulfate and ferric citrate are added. Lactose fermenters, or pink colonies, are distinguished from non-fermenters, or colorless colonies, by the pH indicator neutral red.
Shigella colonies are normally colorless, however Salmonella colonies frequently create colorless to black colonies (because of the creation of hydrogen sulfide). Nonetheless, using biochemical and serological testing to validate the identity of suspected colonies is crucial.
SS Agar has limits even though it’s a useful tool for isolating Shigella and Salmonella. Other intestinal pathogens may sporadically develop on the medium, and certain strains of these pathogens may display unusual colony morphologies. For a conclusive identification, it is therefore advised to employ extra selective and differential media in addition to biochemical and serological testing.
Storage
Keep the container at 15-30 °C and prepared medium at 2-8 °C
| Composition | gr/L |
| Lactose | 10 |
| Bile salts | 8.5 |
| Sodium Thiosulfate | 8.5 |
| Sodium Citrate | 8.5 |
| Beef Extract | 5 |
| Pancreatic digest of Casein | 2.5 |
| Peptic digest of animal tissue | 2.5 |
| Ferric citrate | 1 |
| Neutral Red | 0.025 |
| Brilliant Green | 0.00033 |
| Agar | 13.5 |
| Final pH at 25°C | 7.0 ± 0.2 |
| Dehydrated Appearance | Very light buff to pink, free-flowing, homogeneous. |
| Prepared Appearance | Red-orange, slightly opalescent. |
| Reaction of 6.0% Solution at 25°C | pH 7.0 ± 0.2 |
| Incubate at 35 to 37 °C for 24 hours. | |||
| Organism (ATCC) | Recovery | Colony color | H2S |
| Enterococcus faecalis (29212) | Partial inhibition | Colorless | – |
| Escherichia coli (25922) | Partial inhibition | Pink to red | – |
| Salmonella enterica (14028) | Good | Colorless | + |
| Shigella flexneri (12022) | Fair to good | Colorless | – |